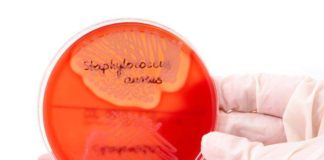

- Цікаве
- Новини
- Різне
- Anastasia Beverly Hills
- ARAVIA
- Belweder
- Boadicea the Victorious
- Clarins
- DirectaLab
- Don’t Touch My Skin
- Estee Lauder
- evergreen
- General
- Gucci
- Lina
- MAC
- Maison Martin Margiela
- Maxclinic
- Melt Cosmetics
- Olaplex
- Plazan
- Rare Beauty
- Астрология
- Беременность и роды
- Будинок
- Бьюти-гид
- в группе
- Вкусные десерты с фото
- Вопрос-ответ
- Воспитание
- Воспитание детей
- Выгодно и полезно
- ВЫПЕЧКА
Українська